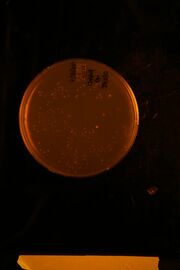

Uploads by Tahoura Samad
From OpenWetWare
Jump to navigationJump to search
This special page shows all uploaded files.
| Date | Name | Thumbnail | Size | Description |
|---|---|---|---|---|
| 00:58, 5 September 2014 | IMG 0916-1.JPG (file) |  |
2.49 MB | |
| 22:01, 17 November 2010 | 20101118 783.JPG (file) |  |
656 KB | |
| 01:19, 15 September 2010 | 20100915 204.JPG (file) |  |
632 KB | |
| 20:34, 10 August 2010 | IMG 5844.JPG (file) |  |
697 KB | |
| 01:02, 5 August 2010 | IMG 5775.JPG (file) |  |
671 KB | |
| 23:32, 4 August 2010 | IMG 5767.JPG (file) |  |
705 KB | |
| 21:01, 3 August 2010 | IMG 5736.JPG (file) |  |
669 KB | |
| 16:26, 30 July 2010 | IMG 5310.JPG (file) |  |
546 KB | |
| 16:26, 30 July 2010 | IMG 5309.JPG (file) |  |
557 KB | |
| 16:26, 30 July 2010 | IMG 5308.JPG (file) |  |
559 KB | |
| 16:25, 30 July 2010 | IMG 5307.JPG (file) |  |
522 KB | |
| 16:24, 30 July 2010 | IMG 5306.JPG (file) |  |
521 KB | |
| 16:19, 30 July 2010 | IMG 5474.JPG (file) |  |
602 KB | |
| 20:53, 27 July 2010 | IMG 5571.JPG (file) |  |
33 KB | |
| 19:14, 27 July 2010 | IMG 5567.JPG (file) |  |
691 KB | |
| 23:09, 21 July 2010 | ConorGel62.jpg (file) |  |
59 KB | |
| 22:21, 21 July 2010 | IMG 5472.JPG (file) |  |
690 KB | |
| 22:21, 21 July 2010 | IMG 5467.JPG (file) |  |
677 KB | |
| 22:18, 21 July 2010 | IMG 5475.JPG (file) |  |
558 KB | |
| 22:17, 21 July 2010 | IMG 5476.JPG (file) |  |
550 KB | |
| 22:16, 21 July 2010 | IMG 5477.JPG (file) |  |
554 KB | |
| 18:16, 13 July 2010 | IMG 5276.JPG (file) |  |
668 KB | |
| 21:20, 9 July 2010 | IMG 5247.JPG (file) |  |
560 KB | |
| 21:19, 9 July 2010 | IMG 5245.JPG (file) |  |
789 KB | |
| 00:37, 9 July 2010 | IMG 5235.JPG (file) |  |
637 KB | |
| 00:34, 9 July 2010 | IMG 5234.JPG (file) |  |
628 KB | |
| 00:33, 9 July 2010 | IMG 5233.JPG (file) |  |
615 KB | |
| 21:09, 8 July 2010 | IMG 5213.JPG (file) |  |
737 KB | |
| 23:33, 7 July 2010 | Stage 1 Col PCR Parts 77-79 7-7-10.jpg (file) |  |
54 KB | |
| 21:17, 7 July 2010 | ConorGel44.jpg (file) |  |
71 KB | |
| 20:10, 7 July 2010 | IMG 5183.JPG (file) |  |
664 KB | |
| 22:27, 6 July 2010 | IMG 5167.JPG (file) |  |
602 KB | |
| 22:42, 2 July 2010 | IMG 5134.JPG (file) |  |
552 KB | |
| 22:42, 2 July 2010 | IMG 5133.JPG (file) |  |
517 KB | |
| 22:41, 2 July 2010 | IMG 5132.JPG (file) | |
559 KB | |
| 22:40, 2 July 2010 | IMG 5131.JPG (file) |  |
560 KB | |
| 22:40, 2 July 2010 | IMG 5130.JPG (file) |  |
521 KB | |
| 22:38, 2 July 2010 | IMG 5129.JPG (file) |  |
552 KB | |
| 22:35, 2 July 2010 | IMG 5128.JPG (file) |  |
548 KB | |
| 00:20, 30 June 2010 | IMG 5072.JPG (file) |  |
526 KB | |
| 00:19, 30 June 2010 | IMG 5073.JPG (file) |  |
560 KB | |
| 00:18, 30 June 2010 | IMG 5074.JPG (file) |  |
542 KB | |
| 00:18, 30 June 2010 | IMG 5075.JPG (file) |  |
516 KB | |
| 00:16, 30 June 2010 | IMG 5076.JPG (file) |  |
510 KB | |
| 18:36, 29 June 2010 | IMG 5015.JPG (file) |  |
575 KB | |
| 17:12, 22 June 2010 | IMG 4959.JPG (file) |  |
547 KB | |
| 17:12, 22 June 2010 | IMG 4960.JPG (file) |  |
572 KB | |
| 17:10, 22 June 2010 | IMG 4961.JPG (file) |  |
531 KB | |
| 17:05, 22 June 2010 | IMG 4956.JPG (file) |  |
503 KB | |
| 17:04, 22 June 2010 | IMG 4957.JPG (file) |  |
469 KB |